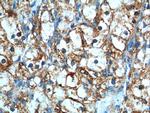
CAMK2 Antibody in Immunohistochemistry (Paraffin) (IHC (P))

Search
Proteintech
CAMK2 Polyclonal Antibody
{{$productOrderCtrl.translations['antibody.pdp.commerceCard.promotion.promotions']}}
{{$productOrderCtrl.translations['antibody.pdp.commerceCard.promotion.viewpromo']}}
{{$productOrderCtrl.translations['antibody.pdp.commerceCard.promotion.promocode']}}: {{promo.promoCode}} {{promo.promoTitle}} {{promo.promoDescription}}. {{$productOrderCtrl.translations['antibody.pdp.commerceCard.promotion.learnmore']}}
产品信息
13730-1-AP
种属反应
已发表种属
宿主/亚型
分类
类型
抗原
偶联物
形式
浓度
规格
纯化类型
保存液
内含物
保存条件
运输条件
产品详细信息
The antibody 13730-1-AP recognizes all the members of CAMK2 family.
Immunogen sequence: MATITCTRF TEEYQLFEEL GKGAFSVVRR CVKVLAGQEY AAKIINTKKL SARDHQKLER EARICRLLKH PNIVRLHDSI SEEGHHYLIF DLVTGGELFE DIVAREYYSE ADASHCIQQI LEAVLHCHQM GVVHRDLKPE NLLLASKLKG AAVKLADFGL AIEVEGEQQA WFGFAGTPGY LSPEVLRKDP YGKPVDLWAC GVILYILLVG YPPFWDEDQH RLYKQIKAGA YDFPSPEWDT VTPEAKDLIN KMLTINPSKR ITAAEALKHP WI (1-271 aa encoded by BC040457)
靶标信息
The Ca2+/calmodulin-dependent protein kinases (CaM kinases) comprise a structurally related subfamily of serine/threonine kinases which include CaMKI, CaMKII and CaMKIV. CaMKII is an ubiquitously expressed serine/threonine protein kinase that is activated by Ca2+/calmodulin (CaM) binding and autophosphorylation and has been implicated in regulation of the cell cycle and transcription. It is involved in dendritic spine and synapse formation, neuronal plasticity and regulation of sarcoplasmic reticulum Ca2+ transport in skeletal muscle. In neurons, plays an essential structural role in the reorganization of the actin cytoskeleton during plasticity by binding and bundling actin filaments in a kinase-independent manner.
仅用于科研。不用于诊断过程。未经明确授权不得转售。
生物信息学
蛋白别名: alpha CaM kinase II; alpha-CaMKII; alternatively spliced; Ca++/calmodulin-dependent protein kinase 2 delta subunit; Ca++/calmodulin-dependent protein kinase II beta subunit; Ca++/calmodulin-dependent protein kinase II delta subunit; Ca++/calmodulin-dependent protein kinase II, delta subunit; Ca2+/calmodulin-dependent protein kinase II; Ca2+/calmodulin-dependent protein kinase II alpha; Calcium, calmodulin-dependent protein kinase; Calcium, calmodulin-dependent protein kinase II; Calcium, calmodulin-dependent protein kinase, type II; calcium/calmodulin-dependent protein kinase (CaM kinase) II alpha; calcium/calmodulin-dependent protein kinase (CaM kinase) II beta; calcium/calmodulin-dependent protein kinase (CaM kinase) II delta; calcium/calmodulin-dependent protein kinase (CaM kinase) II gamma; calcium/calmodulin-dependent protein kinase II alpha subunit; calcium/calmodulin-dependent protein kinase II alpha-B subunit; calcium/calmodulin-dependent protein kinase type II alpha chain; calcium/calmodulin-dependent protein kinase type II beta chain; calcium/calmodulin-dependent protein kinase type II delta chain; calcium/calmodulin-dependent protein kinase type II gamma chain; Calcium/calmodulin-dependent protein kinase type II subunit alpha; Calcium/calmodulin-dependent protein kinase type II subunit beta; Calcium/calmodulin-dependent protein kinase type II subunit delta; Calcium/calmodulin-dependent protein kinase type II subunit gamma; CaM kinase II; CaM kinase II alpha subunit; CaM kinase II beta subunit; CaM kinase II delta subunit; CaM kinase II subunit alpha; CaM kinase II subunit beta; CaM kinase II subunit delta; CaM kinase II subunit gamma; CaM-kinase II alpha chain; CaM-kinase II beta chain; CaM-kinase II delta chain; caM-kinase II gamma chain; CaMK II; CaMK-II alpha subunit; CaMK-II delta subunit; caMK-II subunit alpha; caMK-II subunit beta; caMK-II subunit delta; caMK-II subunit gamma; proline rich calmodulin-dependent protein kinase; protein kinase homolog; unnamed protein product
基因别名: 2810011D23Rik; 8030469K03Rik; [d]-CaMKII; CAM2; CAMK; CaMK II; CAMK-II; CAMK1; CAMK2; CAMK2A; CAMK2B; CAMK2D; CAMK2G; CAMKA; CAMKB; CAMKD; CAMKG; Camki; CaMKII; CaMKIIalpha; CaMKIIbeta; CaMKIINalpha; Ck2b; KIAA0968; Kiaa4163; mKIAA0968; MRD53; MRD54; MRD59; MRT63; PK2CDD; PKCCD; R74975; RATCAMKI
UniProt ID: (Human) Q9UQM7, (Human) Q13554, (Human) Q13557, (Human) Q13555, (Mouse) P11798, (Rat) P11275, (Rat) P08413, (Mouse) P28652, (Rat) P15791, (Mouse) Q6PHZ2, (Mouse) Q923T9, (Rat) P11730
Entrez Gene ID: (Human) 815, (Human) 816, (Human) 817, (Human) 818, (Mouse) 12322, (Rat) 25400, (Rat) 24245, (Mouse) 12323, (Rat) 24246, (Mouse) 108058, (Mouse) 12325, (Rat) 171140